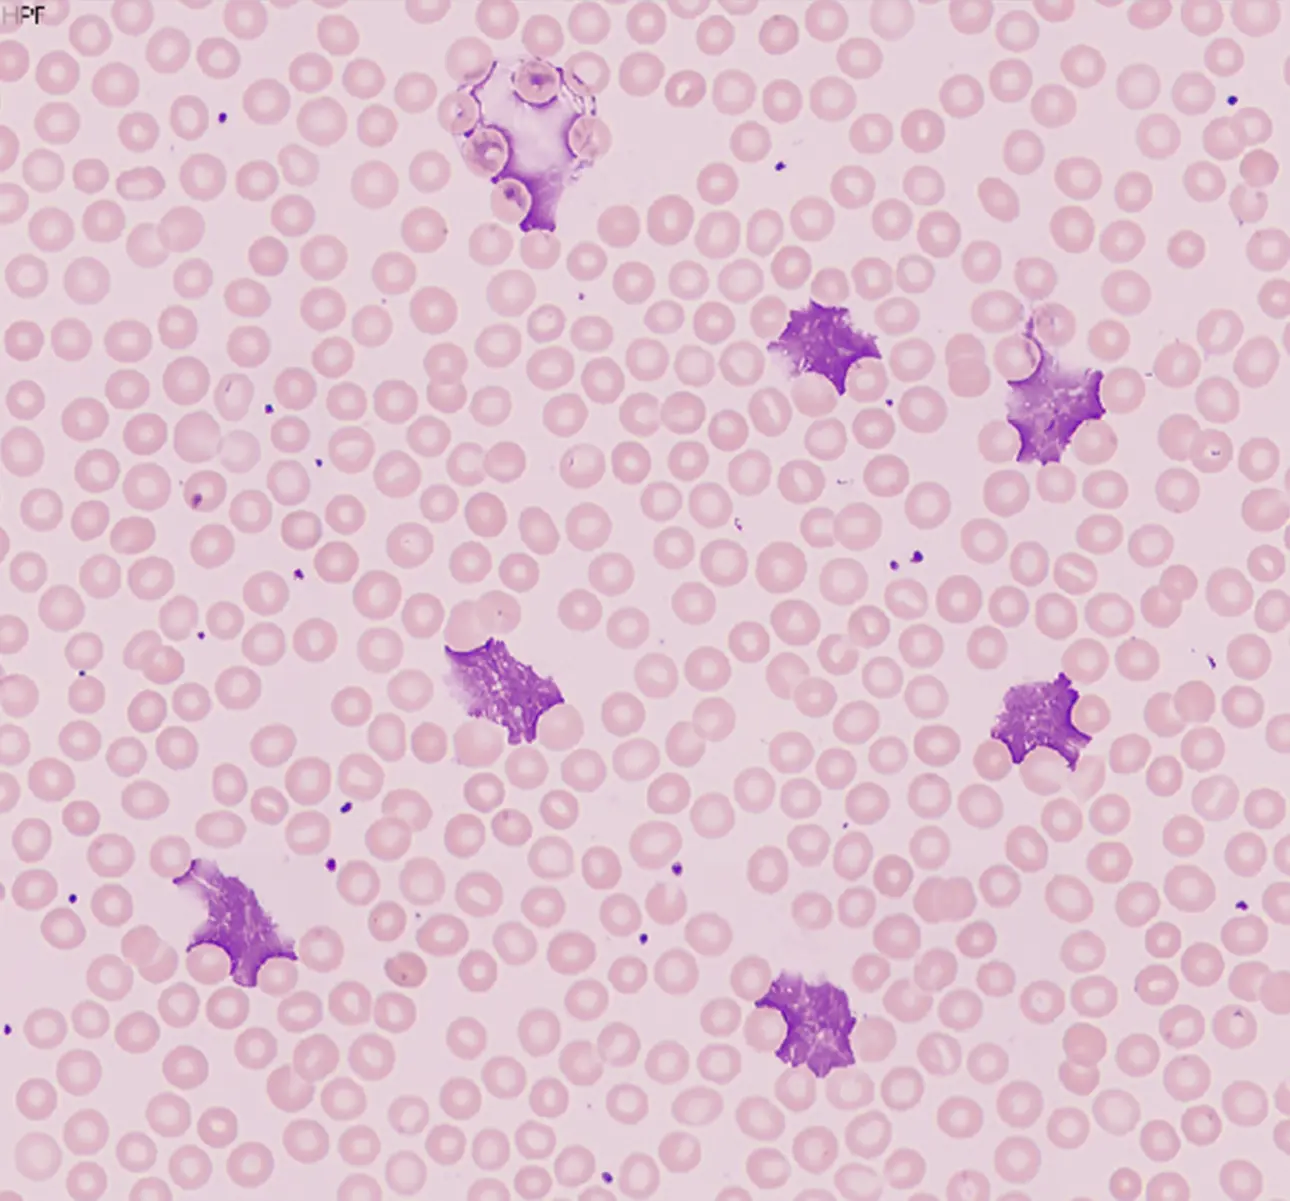
chronic-lymphocytic-leukemia-case-study-fig5

Clinical information
The patient, a 74-year-old male with chronic lymphocytic leukemia, revisited the hematology clinic outpatient department for further treatment and evaluation.
CBC results
The results of the BC-6800 Plus blood routine test showed a significant increase in the total white blood cell count, with a classification result of N: 13.6%, L: 84.6%, and M: 1.5%. The lymphocyte ratio was increased, while the neutrophil and monocyte ratios were decreased. The BC-6800 Plus alarm message was Abn Lymph/blasts? and WBC Abn Scattergram (as shown in Figure 1), triggering the re-examination rules [1,2], and requiring a review of the blood smear under the microscope.

Peripheral blood morphology examination
According to the re-examination rules, after using the fully automated SC-120 slide maker and stainer of the Mindray CAL 8000, and followed by the digital cell morphology analyzer MC-80, no abnormal cells or blasts were found. The morphology of the neutrophils and lymphocytes were normal, as were the morphology and quantity of red blood cells and platelets. However, the pre-classification result of the MC-80 showed an increase in the neutrophil ratio to 57.5% and a decrease in the lymphocyte ratio to 33% (as shown in Figures 2 and 3), which is in stark contrast to the BC-6800 Plus classification result of N: 13.6%, L: 84.6%. Why were lymphocytes missing in such large numbers? Where did the missing lymphocytes go? Should we report the result based on the BC-6800 Plus or the MC-80?


Case analysis
In the work of hematology analysis, timely rerun and morphological review [3-5] of samples that trigger the re-examination rules based on the international 41 rules and the Chinese expert consensus on blood cell morphology analysis are necessary guarantees to ensure the accuracy and reliability of the test results. However, when the author reviewed the peripheral blood smear of the patient using the MC-80 for pre-classification, it was found to be in stark contrast to the results of the blood cell analyzer. Even after reviewing all the white blood cell morphology images one by one, no errors in white blood cell pre-classification were found, which left the author deep in thought and confusion. Is the microscopic white blood cell classification result, which is considered the gold standard, unreliable? Upon rechecking the patient's basic information and carefully observing the MC-80 pre-classification result, a large number of smudge cells were found in the non-white blood cell area. A total of 1,295 smudge cells were found in 200 classified white blood cells (as shown in Figure 4).

It turned out that the 'missing' lymphocytes were destroyed during the slide making process, forming smudge cells. These smudge cells are traditionally excluded from white blood cell classification and counting, and are not included in the total count. However, the MC-80 processes them differently by not excluding these cells, but classifying them as non-white blood cell categories. Considering that the patient in this case was diagnosed with chronic lymphocytic leukemia, in which lymphocytes account for the majority and become more fragile, smudge cells are easily formed during slide making, resulting in the loss of a large number of cells during classification and counting. This explains the difference between the microscopic classification result and the blood cell analyzer classification result. Thus, the doubts disappeared, and the questioning of the gold standard of microscopic classification of blood routine also disappeared. The MC-80's processing method is more conducive to reflecting the true picture of the peripheral blood smear, providing an opportunity for comprehensive observation and real classification, and can provide strong evidence for medical disputes if necessary.
Summary
In recent years, the use of digital morphology analyzer has greatly improved the efficiency and quality of morphological review, reduced the workload, and enabled better execution of blood routine re-examination work. However, in actual work, we have also encountered some confusion. In this case where the blood cell analyzer showed the lymphocyte classification as high as 84.6%, but the microscopic classification result was only 33%. This difference is obviously unreasonable. What is the reason? Firstly, the traditional white blood cell classification counting principle will exclude smudge cells. However, in practice, smudge cells should not be excluded when classifying and counting white blood cells on the basis of clarifying the nature and source of the smudge cells, but should be included and classified in the report. Secondly, when reviewing the results of digital morphology analyzer, we should not only focus on the classification of white blood cells, the morphology of red blood cells, and the morphology and quantity of platelets, but also pay attention to non-white blood cell components such as smudge cells, nucleated red blood cells, large platelets, aggregated platelets, megakaryocytes, sediment, etc. These components may provide important clues for the diagnosis of certain diseases. Finally, we need to understand the patient's basic information and communicate fully with the clinical doctor when necessary to make a more scientific diagnosis.
What is Chronic Lymphocytic Leukemia (CLL)
Chronic lymphocytic leukemia (CLL) is a type of cancer that affects the blood and bone marrow. It is characterized by the accumulation of lymphocytes, a type of white blood cell, which do not function properly and do not die when they should. These abnormal cells can build up in the blood, bone marrow, lymph nodes, and other organs, leading to a variety of symptoms such as fatigue, weakness, enlarged lymph nodes, and frequent infections. CLL is a chronic disease, meaning it develops slowly over time and may not require immediate treatment. However, it can progress and become more aggressive, requiring treatment to manage the symptoms and slow the progression of the disease.

Call for case studies
- Do you want to share your case with us? We will share your case in the upcoming issues with acknowledgement.
- IVD Cases: You are recommended to submit any typical, misdiagnosed, special or rare cases that received a definite diagnosis or successful treatment. Cases that involved effective communication between the laboratory and clinical departments are particularly encouraged.
- Format: You are required to include four sections in your entry: "Case Introduction, Case Details, Case Analysis, and an Executive Summary". The Case Details section must include: primary medical history, positive/negative test results that aided in the diagnosis, and the diagnosis and treatment process.
- Please submit your entry in a Word document (in English) by sending it to hoishan.kwok@mindray.com by May 30, 2024.
- The email should come in a subject that reads: country+name of the entry + name of the applicant.
Reference
[1] 丛玉隆。血细胞分析仪形态学分析技术与镜检筛选[J].中华检验医学杂志.2014,(1).5-8.
[2] 邢莹,闫晓华,普程伟,等。全自动数字图像分析在外周血白细胞形态学复检中的临床应用 [J].中华医学杂志.2016, (8).634-639.
[3] 中华医学会血液学分会实验诊断血液学学组。血细胞形态学分析中国专家共识(2013版)[J].中华血液学杂志.2013, (6).558-560.
[4] 丛玉隆,王昌富,乐家新。血细胞自动化分析仪分析后血涂片复审标准制定的原则与步骤[J].中华检验医学杂志,2008, 31(7): 729-732.
[5] 中华检验医学杂志编辑委员会。全国血液学复检专家小组工作会议纪要暨血细胞自动计数复检标准释义[J]. 中华检验医学杂 志, 2007, 30(4): 380-382.
[6] 姜玉,张建富,王蓉,等。外周血涂片中涂抹细胞与幼稚淋巴细胞的比例在慢性淋巴细胞白血病中的意义[J]. 南京医科大学学报(自 然科学版), 2014, 34(4):495-498.
[7] 彭真萍,王剑飚,郭平,等。外周血片涂抹细胞的实验室解决思路[J]. 检验医学, 2017, 32(6): 520-523.


